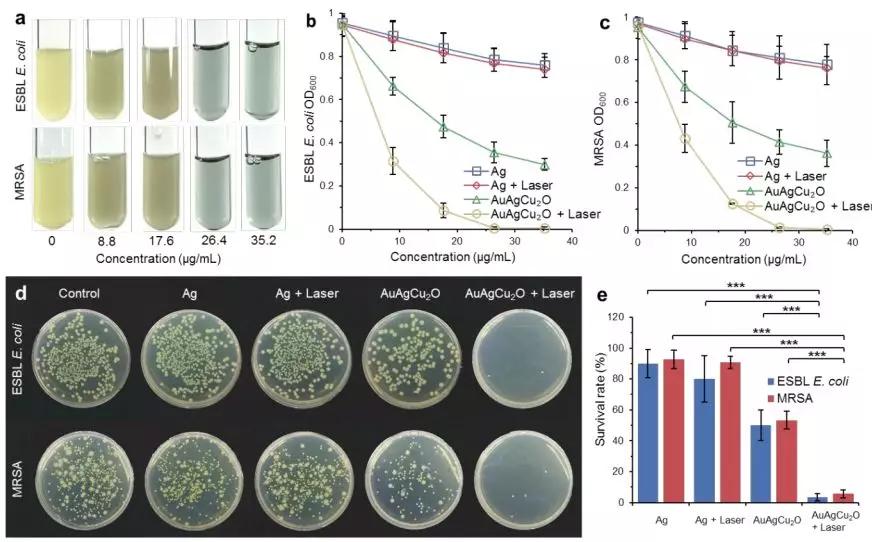
罗非鱼感染嗜水气单胞菌怎样治疗,罗非鱼病毒

文 | 十一情报局
编辑 | 十一情报局

●—前言—●
罗非鱼因生长快、食性杂、病害少、肉质好、产量高等优点, 已被引入中国、印度尼西亚和埃及等90多个国家并被广泛养殖,预计2021年全球罗非鱼产量将达到729万t,为仅次于鲤科鱼类的全球第二大养殖鱼类。

中国是罗非鱼的主要养殖和生产基地,养殖量约占全球30%,罗非鱼具有较强的抗病性和抗逆性,适合集约化养殖系统,是一种廉价的蛋白质来源, 但近年来罗非鱼病害频生,给全球罗非鱼养殖产业造成了巨大的经济损失,严重制约罗非鱼产业的可持续发展。

其中,自2009年开始,在以色列、厄瓜多尔、埃及、泰国、印度等多国相继暴发的种新发疫病一-罗非鱼湖病毒病( Tilapia LakeVirus Disease,TiLVD ),给全球罗非鱼养殖业带来巨大威胁和严峻挑战。
该病病原为一种新型RNA病毒一罗非鱼湖病毒 (Tilapia Lake Virus,TiLV),目前,对于TLV致病机制、TiLV基因组中各节段基因功能均不清楚,对TiLVD尚无有效的防控措施,因此,针对 TLV 的单抗抗体制备对于TLV 病原学研究及TiLVD防控均具有重要意义。

TiLV是种包膜病毒其基因组由10个单股负链RN*片A**段组成,共编码14个功能蛋白,目前,国际病毒分类委员会 ( International Commitee on Taxonomy of Viruses ICVT) 将TiLV作为一个新种,单独列为罗非鱼湖病毒属、罗非鱼病毒新科。
Til-4-2011是第一个完成全基因组测序的TiLV分离株,其S1节段包含1个与正粘病毒科C型流感病毒(ICV )PB1亚基具有序列同源性的开放读码框, 最初将TiLV确定为一种新型正粘病毒样病毒。

后续研究表明,S1、S2、S4和 S5 节段与Dhari病毒有很强的同源性,S6、S7 和 S8 与流感病毒进化上接近,而S3阶段与传染性鲜鱼贫血病毒有较弱的同源性。
TiLV各基因节段编码的蛋白功能均未知,生物信息学分析和预测表明,TLV S10基因节段编码的蛋白含有一个澳结构域,澳结构域是一类保守的蛋白质结构域, 能特异性识别乙酷化赖氨酸并形成驱动活性转录的蛋白质复合物,从而调节基因转录。

相比于其他9种蛋白,TiLV S10编码蛋白具有更丰富的抗原表位提示S10编码蛋白具有更强的免疫原性。
罗非鱼对TiLV高度敏感,在各个养殖阶段都能受TiLV感染,以早期发育阶段的发病率和死亡率相对更高,死亡率在20%~90% 之间,水平传播是罗湖病毒重要的传播途径之一,健康鱼可通过受TiLV污染的水和设备感染TiLv。
感染鱼的肠道中和粪便中均可检测到TiLV基因组RNA,表明极有可能存在粪口传播途径,近年来的研究表明,在2日龄鱼苗中检测到TLV, 在病鱼生殖器官中也能检出TiLV 基因组RNA和活病毒,表明TiLV可能存在垂直传播途径。

迄今为止,针对TiLV的感染尚无有效的防治办法,加强TiLV病原学基础研究、开发高效的疫苗和有效的防治药物是当前TiLVD防控研究的热点和重点。

●—实验材料和方法—●
在实验中需要用到pET-32a( +)载体、小鼠骨髓细胞(SP2/0)均为中国水产科学研究院珠江水产研究所病害防控与免疫实验室保存;用于增殖TLV的TB细胞系由该实验室建立并保存。

Escherichiacol DH5 a和Ecoli BL21感受态细胞购自北京康为世纪生物科技有限公司,6周龄SPF唯性BALB/c小鼠购自广东省实验动物中心,异丙基硫代半乳糖昔(IPTG )、异硫氰酸荧光素(FITC )标记的羊抗兔IgG、FITC标记的羊抗鼠。
IgG、HRP标记羊抗鼠1gG、HT、HAT、弗氏完全佐剂弗氏不完全佐剂和PEG3350均购自Sia-aldrich西格玛奥德里奇(上海) 贸易有限公司,RPMI-1640培养基、胎牛血清、DMEM-20 完全培养基、蛋白质 Marker、RIPA 裂解液、限制性核酸内切酶( BamH I和 Hind I )和T4 DNA 连接酶购自赛默飞世尔科技(中国)有限公司。

MiniBEST DNAFragment Purification Kit 、Prime STAR Max DNAPolymerase 购自宝生物工程(大连)有限公司,质粒提取试剂盒、胶回收试剂盒均购自广州飞扬生物工程有限公司,SDS-PAGE 试剂盒、超敏化学发光显色液购自新赛美生物科技有限公司,小鼠单克隆抗体亚型鉴定试剂盒购自武汉三鹰生物技术有限公司。

根据TiLVS10全长基因序列( GenBank 登录号:KU751823.1) 设计PCR引物,S10-F 序列: 5GCT GGA TCC ATG AGT GTG GCA GAT TAT 3(下划线为 BamH I 酶切位点 ),S10-R序列5' GCG AAG CTT ACGTCA AGA GAC TTC TTC C 3(下划线为 Himd I酶切位点)。

以中国水产科学研究院珠江水产研究所病害防控与免疫实验室保存的TiLVcDNA为模板,使用引物组S10 F/R扩增目的基因片段,PCR反应程序为95C预变性3min; 95 ℃变性30 s、55 ℃退火 30 s、72℃延伸30 s,共35个循环;72 ℃后延伸 10 min。
PCR扩增产物经琼脂糖凝胶回收后与pET32a载体分别用BamH I和Hind 亚限制性内切酶在37℃下双酶切 20 min,然后分别进行纯化回收。

回收产物按比例配置好连接体系后,在T4 DNA连接酶作用下22℃连接20 min,然后转化E.coli DH5a感受态细胞。
挑取单菌落进行酶切验证,验证正确后送至上海生工生物工程( 上海)股份有限公司进行测序鉴定,鉴定正确的质粒即为pET32a-S10,扩大培养后于-20℃保存备用。
将重组质粒pET32a-S10转化至E.coli BL21 ( DE3) 感受态细胞,挑取单菌落于含氨节青霉素的LB液体培养基中培养至菌液OD600值为0.6左右时,添加终浓度为0.1 mmolL的IPTG于28 ℃条件下诱导表达(未诱导组不加IPTG)。

将诱导表达后的重组菌液于10000 r/min、4℃离心8 min收集菌体,按100 mL裂解缓冲液(500 mmal/L NaCl.20 mmol/L Tris,5% 甘油,1%Triton100,pH 值8.0 )与1L重组菌液的体积比进行重悬,冰浴条件下以超声波破碎30 min,10 000 /min、4℃离心30 min,分别收集上清及沉淀,将收集的上洁用镍柱进行纯化。

收集不同浓度咪哗洗脱的洗脱产物进行SDS-PAGE 检测,分析蛋白纯化效果并利用 BCA法测定目的蛋白浓度,将纯化好的 S10重组蛋白分装后置于-80℃保存备用。
用纯化的S10重组蛋白与等体积的弗氏完全佐剂混合乳化完全后,皮下注射BALB/c 小鼠,每只小鼠的免疫剂量为100g重组蛋白。

2周后进行第2次免疫, 取等体积的弗氏不完全佐剂与纯化的S10重组蛋白均乳化后进行皮下注射,免疫剂量与第1次免疫相同。
二免后2周和4周分别进行第3、4次免疫,方法和剂量与第2次免疫相同,第4次免疫1周后,尾静脉采血测定抗血清效价,效价达到1 : 10000以上时用100µgS10重组蛋白直接腹腔注射BALB/c 小鼠加强免疫。

之后进行杂交瘤细胞株的克隆与筛选,并通过MAb进行纯化和亚型鉴定,然后用ELISA间接检测MAb效价,最后分别用Western-blot和IFA来鉴定MAb特异性。

●—实验结果分析—●
以S10基因序列为模板进行PCR扩增,产物经1.5%琼脂糖凝胶电泳,结果(图 1)显示,在300-400 bp之间可见一条特异性条带,与预期目的片段314bp结果相符。BamHI和Hind I双酶切后也出现约314 bp的条带,与预期结果相符。
测序结果进一步证实扩增片段与S10基因序列一致,说明重组质粒构建成功,并将其命名为pET32a- S10。

将重组质粒pET32a - S10转化E.coli BL21( DE3)感受态细胞内,在28℃条件下IPTG 诱导表达12 h后,经SDS-PAGE电泳,结果(图2)显示,与未诱导组相比,诱导组在40 ku与30ku之间有一条特异的蛋白条带,与预期的蛋白分子质量大小一致,且蛋白在上清和包涵体中均获得表达。
经镍柱纯化后的目的蛋白纯度较高,条带单一无明显杂带。

将骨髓瘤细胞SP20与免疫小鼠脾细胞融合后经过4次亚克隆,利用间接ELISA方法对上清进行检测,筛选出2株可稳定分抗TiLV- S10蛋白的MA杂交瘤细胞株,分别命名为2C3和2E3。
用小鼠单克隆抗体亚型鉴定试剂盒对其分泌的抗体进行亚型鉴定,结果显示,2C3抗体为IgG1/K型,2E3抗体为IgG2a/k型。

2C3和2E3腹水抗体纯化后浓度分别为1.05、1.14 mg/mL,抗体稀释200倍后进一步倍比稀释,用间接 ELISA 法测定制备的杂交瘤细胞株效价.空白对照OD450值为0.114,结合酶联结果阳性判断标准,得出2C3和2E3腹水抗体效价分别为1 : 12800、1 : 51200。
以空载蛋白为阴性对照,S10重组蛋白以及纯化的TiLV经由SDS-PAGE后转印至NC 膜上以纯化后的2C3和2E3MA为一抗,HRP 标记的羊抗鼠IgG为二抗。
结果(图3)显示, 2C3和2E3MAb均能与S10蛋白和纯化的TiLV 发生反应目的条带约为38 ku,与预期结果相符,表明制备的2C3和2E3 MAb均可特异性识别TiLV。

以制备的2C3和2E3 MAb作为一抗,与感染TiLV的TiB细胞和未感染TLV的TB细胞进行IIFA试验鉴定,结果(图4)显示,2C3和2E3能对病毒感染的TiB细胞产生特异性的绿色荧光,与未感染病毒的TiB细胞呈现阴性反应, 说明制备的2C3和2E3两株抗S10蛋白MA具有良好的特异性。


●—结论—●
在实验中我们成功 构建了含有TiLV基因组S10节段的原核表达载体pET32a-S10 ,经 IPTG诱导可表达出大小约为38 ku的目的重组蛋白。

利用纯化的重组蛋白免疫小鼠,经多轮筛选和鉴定,最终获得2株能够分泌抗S10编码蛋白MA的杂交瘤细胞株,其编号分别为2C3、2E3。
其中2C3细胞株分泌的抗体为IgG1/ k 型,2E3分泌的抗体为IgG2a/k型,2株细胞株经注射小鼠制备的MAb效价分别为1 : 12800 和1 : 51200。

经Wester blot和IFA分析证实,2种MAb均能与TiLV特异性反应,实验中制备的MA 特异性好抗体效价高,可为后续TiLVS10蛋白结构功能研究、TiLV疫苗研发、治疗手段以及诊断试剂的开发提供重要基础材料。